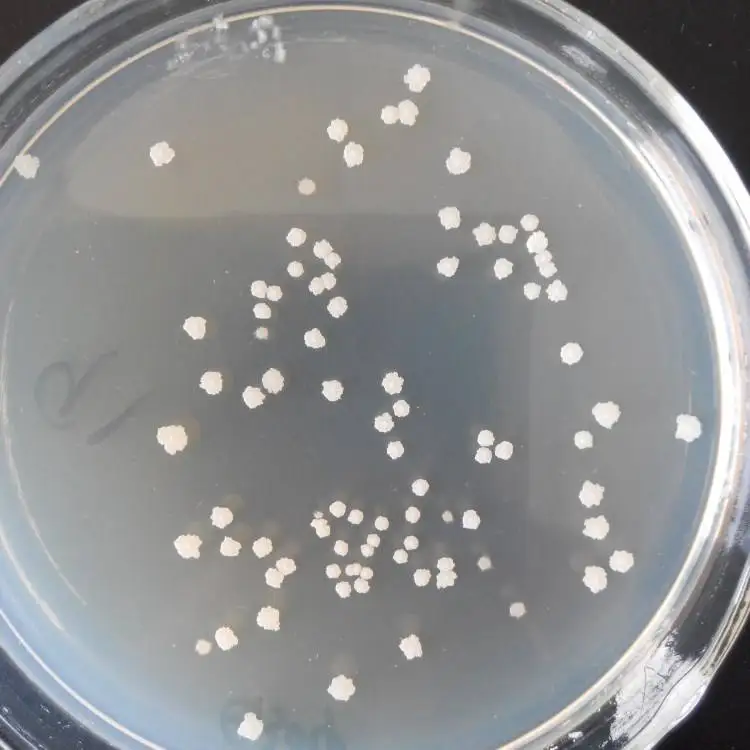
Bacillus amyloliquefaciens
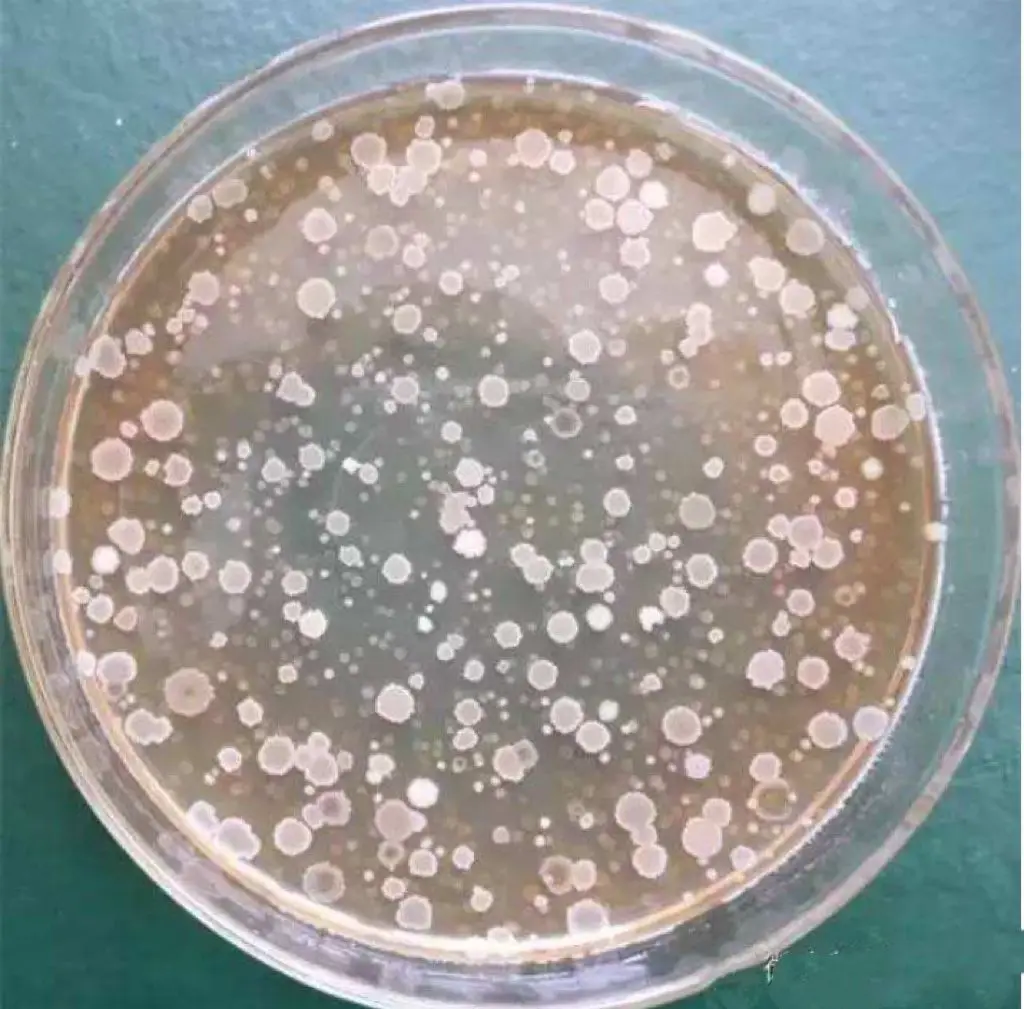
Bacillus amyloliquefaciens

Bacillus amyloliquefaciens
- Category: Microecology >>>
- Supplier: Hebei Green Element Biotechnology Co. Ltd.
Share on (1600439088651):
Product Overview
Description
Product Description
Specification
item | value |
Type | Microbial agent |
Product name | Bacillus amyloliquefaciens |
Appearance | Light Yellow Powder |
Grade | Feed Garde |
Sample | Avaiable |
Solubility | 100% water soluble |
Storage | Cool Dried Storage |
Delivery time | Within 10 Working Days |
Odour | Slight Fermentation Odour |
Packing & Delivery


1kg/2KG/5KG/10KG/25KG ( Foil bag or cardboard drum )
Relying on a strong technical production team, a professional import and export company was established.
Look for the most advanced technology and products abroad, while promoting our latest products and R&D achievements.
Look for the most advanced technology and products abroad, while promoting our latest products and R&D achievements.
Manufacturing Technique




FAQ
1. who are we?
We are based in Hebei, China, start from 2021,sell to North America(70.00%),Southeast Asia(10.00%),Eastern Asia(10.00%),Western Europe(5.00%),South America(5.00%). There are total about 1-4 people in our office.
2. how can we guarantee quality?
Always a pre-production sample before mass production;
Always final Inspection before shipment;
3.what can you buy from us?
Microbial agents,Biological Products,Enzyme,Plant fertilizer,Feed additives
4. why should you buy from us not from other suppliers?
Professional technical staff
Sales manager with 20 years of experience in import and export business
Awesome services
Best quality in its class No low quality products sold
5. what services can we provide?
Accepted Delivery Terms: FOB,CIF,Express Delivery,DAF;
Accepted Payment Currency:USD;
Accepted Payment Type: T/T,MoneyGram,Credit Card,Western Union,Cash;
Language Spoken:English,Chinese
We are based in Hebei, China, start from 2021,sell to North America(70.00%),Southeast Asia(10.00%),Eastern Asia(10.00%),Western Europe(5.00%),South America(5.00%). There are total about 1-4 people in our office.
2. how can we guarantee quality?
Always a pre-production sample before mass production;
Always final Inspection before shipment;
3.what can you buy from us?
Microbial agents,Biological Products,Enzyme,Plant fertilizer,Feed additives
4. why should you buy from us not from other suppliers?
Professional technical staff
Sales manager with 20 years of experience in import and export business
Awesome services
Best quality in its class No low quality products sold
5. what services can we provide?
Accepted Delivery Terms: FOB,CIF,Express Delivery,DAF;
Accepted Payment Currency:USD;
Accepted Payment Type: T/T,MoneyGram,Credit Card,Western Union,Cash;
Language Spoken:English,Chinese
We Recommend
New Arrivals
New products from manufacturers at wholesale prices